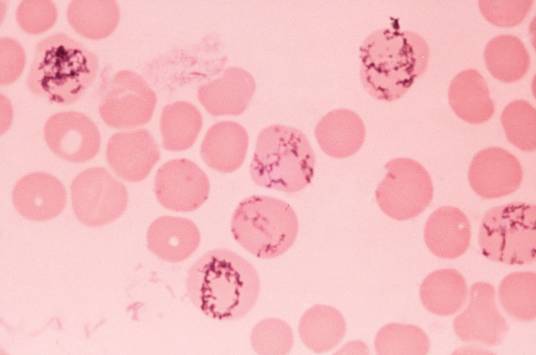

-
网织红细胞 编辑
网织红细胞是尚未完全成熟的红细胞,在周围血液中的数值可反映骨髓红细胞的生成功能,因而对血液病的诊断和治疗反应的观察均有其重要意义。
网织红细胞(Reticulocyte,Ret)是红细胞的未成熟阶段,是反映骨髓红系造血功能以及判断贫血和相关疾病疗效的重要指标。
中文名:网织红细胞
外文名:Reticulocyte
反映:骨髓红系造血功能
阶段:红细胞的未成熟
重要指标:判断贫血
分裂:7-8次
网织红细胞
网织红细胞
(二)方法 活体染色法.近年来还可通过某些血液自动分析仪及流式细胞术检测法进行网织红细胞计数。
(三)参考值(活体染色法)
成人和儿童 0.005-0.015 新生儿 0.02-0.06 网织红细胞绝对值(24-84)×10^9/L
(四)临床意义
网织红细胞计数反应骨髓造血功能的重要指标。
网织红细胞增多表示骨髓红系增生旺盛,常见于溶贫、急性失血、缺铁贫、巨幼贫等,网织红细胞减少表示骨髓造血功能减低,常见于再障、骨髓病性贫血。
(1)提示骨髓造血功能旺盛 见于各种增生性贫血如缺铁性贫血、巨幼细胞性(缺乏叶酸、维生素B12)贫血、失血性贫血,尤以溶血性贫血时增加最为显著,常>10%。
(2)缺铁性贫血在给予铁剂、维生素B12、叶酸治疗之后,可见网织红细胞明显增加。
提示骨髓造血功能低下,见于再生障碍性贫血、巨幼细胞性贫血、急性白血病。
网织红细胞计数在诊断正常细胞贫血,或仅蛋白、转铁蛋白结果可以的小细胞时尤为重要;大细胞贫血伴网织红细胞增多,常提示用叶酸或维生素B12治疗有效。
1、本站所有文本、信息、视频文件等,仅代表本站观点或作者本人观点,请网友谨慎参考使用。
2、本站信息均为作者提供和网友推荐收集整理而来,仅供学习和研究使用。
3、对任何由于使用本站内容而引起的诉讼、纠纷,本站不承担任何责任。
4、如有侵犯你版权的,请来信(邮箱:baike52199@gmail.com)指出,核实后,本站将立即删除。